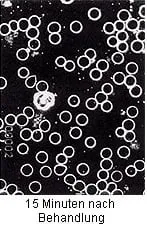
QRS FAQs

EMF VS PEMF
EMF is an electromagnetic field that is constantly bombarding our bodies 24/7 with damage at the cellular level. PEMF is a pulsed magnetic field designed to mimic the Earth’s naturally healing magnetic field.
We Are Only As Healthy As Our Cells
A session on the QRS Full Body Mat improves blood circulation, increases oxygenation of the cells and tissue, and improves mitochondrial function resulting in increased energy. the positive effect increases with consistent use.

Mode of action on the organism by QRS ® on vital blood of a 55-years-old female patient with thyroid carcinoma-clear rouleaux formation (J. Mittelbach, practice for naturopathy, Chemnitz) Picture shows the movement of cells before, during, and after treatment
Benefits may include:
– Reduction of chronic pain including back pain, hip pain, knee pain, arthritis, foot pain, neck and shoulder pain, and migraines
-Reduction of inflammation
– Increased relaxation
– Reduction of stress
– Improved sleep
– Increased energy and overall vitality
-Reduction of migraine attacks
– Improved skin health
– Improved kidney function
– Improved eye health
– May have positive effects on
symptoms of metabolic syndrome,
heart disease, neurological disease,
and lung diseases.
-Faster recovery after injury
Certain conditions frequently require a therapy period of 3 to 6 months
Curious? Call Now to set up a session to see what quantum medicine can do for you.

History
Development | Science | Faraday Cage
Development
Biomedical Engineer Bod Dennis developed equipment for NASA to stimulate growth factors in the ’90s. His research led him to discover that Pulsed Electromagnetic Frequency (PEMF) mimics the Earth’s magnetic field and could be used to treat chronic pain. He developed many frequencies to help with different aspects of the human body.
Science
The sun has a frequency that bounces into the Earth, creating the Earth’s natural magnetic field. This magnetic field expands into the atmosphere by 40-50 miles. Its frequency is 7.83 HZ ELF. Dr. Bob Dennis figured out how to mimic the Earth’s magnetic field, thus helping people lessen pain and inflammation in their bodies. His discovery allows people to use PEMF devices to mimic Mother Nature, bringing healing at the cellular level.
Faraday Cage
Anything that blocks the Earth’s magnetic field is called a Faraday cage. Things like metal buildings, rubber-soled shoes, concrete, blacktop, pavement, or any other material block us from benefiting from the Earth’s naturally healing magnetic field. People must be barefoot in the grass or dirt daily to get natural healing from the Earth’s magnetic field. Most cattle or outdoor animals get the correct amount of the Earth’s magnetic field as they are outdoors and not usually under power lines.
One should make Faraday cages to stop the constant debilitating damage from EMFs and protect them from cellular damage. Harmful EMFs are cell phones, cell phone towers, wireless routers, laptop computers, radio frequencies, televisions, microwave ovens, and radar.
Benefits

Healing
PEMF has healing frequencies for many disorders, including nerve regeneration, bone growth, ligament healing, and stimulation for capillary formation.

PTSD
It flows into the area of the brain that is inflamed or stressed with fear responses and reduces the inflammation, providing a calming effect. It has the potential to overturn PTSD, as indicated in studies conducted at NIH.GOV.

Osteoarthritis
Evidence shows that PEMF moves the cells back into homeostasis, reduces inflammation, and promotes bone growth to reverse osteoarthritis.

Depression/Anxiety
PEMF helps the body to relax, improves cellular function, detoxifies the body, and reduces inflammation. People with disturbances like OCD, anxiety, panic, and depression are stuck in a flight or fight the state of being. PEMF calms both the body and the brain and allows the cells to release serotonin, GABA, and endorphins needed to increase mental wellness.

Sleep
The amount of EMF often causes sleep disturbances in the sleeping quarters. EMF is constant and harmful and disturbs the circadian rhythms. They block sleep, which leads to depression, reduced cognitive function, decreased sex drive, increased weight gain, and aging of the skin. PEMF causes the body and brain to relax, and when used in conjunction with removing the EMFs from the sleeping quarters, your health will improve.

Cellular Healing
Cells must be healthy, or the body will fall into illness and disease. Cells need oxygen, movement, and the transport of ions. Reduction in cell energy triggers a metabolic shutdown and prevents normal cell functioning.
PEMF restores normal cell function. It activates the metabolism, stabilizes and enhances the immune system, and promotes cell regeneration. PEMF enables the body to strengthen and return to normal and healthy cell function.

Quantum Resonance System (QRS)
Discovery | Advantages | Differences
Discovery
The QRS difference. The QRS device used in our clinic is a PEMF device with one difference than others on the market. It uses the proven methodologies of quantum medicine. International QRS research has never had any harmful side effects since its establishment in 19990, and over 200,000 units worldwide.
Advantages
Quantum medicine reaches every part of the organism; even the smallest blood vessels become activated. QRS strengthens bones. QRS intensifies the exchange of cellular nutritional and waste products. The reorganization of proteins is accelerated, and the body’s weak electromagnetic field is strengthened and stabilized. QRS stimulates cell regeneration and increases the effectiveness of the immune system.
The QRS brings information about the transport of ions and protons into and out of cells. It is a patented process that supplies the cell with better oxygen and nutrients. It frees the ell from slags and toxins
Differences
The QRS is the only PEMF device on the market with the patented ability to transport hydrogen to bring about calcium, sodium, potassium chlorine, and magnesium ions, creating better cell supply and freeing the cells of waste products and toxins.
QRS significantly increases oxygen in the tissues. The oxygen diffusion rate is increased by 80 to 900%, and ATP, energy molecules, are formed and can transport the materials through solid or slackened tissue structures. Using the QRS device means that you will feel better quickly.
Benefits Continued

Athletes Benefit
Says: Arnie Kander Strength and Conditioning Coach for Professional Athletes
“When it comes to tissue healing and recovery, I have seen a 50% to 70% reduction in healing time and more for an assortment of soft tissue and groin injuries and all sorts of orthopedic musculoskeletal injuries. I have seen wound healing at an incredible rate…75% quicker healing than just the normal standard protocol stuff.”

Speed Healing
Says: JD Drew Red Sox Outfielder interview with Eagle Tribune
“That machine is absolutely amazing. I went into spring training last year with a little bit of inflammation in my knee. I put the QRS machine on it and immediately the swelling was gone. I was like, ‘Wait a minute. That’s really wild.’ I remember a couple times last year where I got hit and Grady (Little) took me out of the game. I told the trainer, ‘No offense to what you guys are doing, but I’ve got a hyperbaric chamber at home and I’ve got a QRS machine. Do you want me to get out of here so I can be in the game tomorrow?”

Peak Performance Business
Says: QRS data: “Half of all managers and 28 percent of employees feel stressed.”
Lack of exercise, improper diet, stress, smoking and alcohol are all factors that weaken our cells constantly increasing the risk for metabolic diseases later.
Regular use of QRS®, activates the metabolism, and improves the absorption of nutrients and minerals. The blood circulation is enriched with more oxygen and thus purifies the body. Tissue and muscles are relaxed.

QRS and The MIR Space Station
Space Travel
The QRS was the chosen PEMF device to go with the astronauts to the MIR Space Stations to protect them from decreased bone density and circulatory problems caused by weightlessness.
Additionally, the QRS system was the chosen PEMF device for the MARS Space Program to travel to the Red Planet.
“In order to maintain good health, our astronauts need to use the QRS on their flight to Mars!” Professor Dr. of Medicine, V. M. Baranov, Medical Director at EUROSPACE in Moscow.
IMAGINE receiving the same benefits as our beloved astronauts, athletes and entrepreneurs in our clinic right now.

Memory/Alzheimer’s
Good News! Get Started Early
PEMF does not directly treat Alzheimer’s but does work at the cellular level, affecting all of our cells, including the brain. Studies show that high and low frequencies, ranging from 5 to 8 HZ, detected significant improvements in Alzheimer’s patients and created benefits, primarily when used regularly. These included improved visual memory, drawing performance, spatial orientation, mood, short-term memory, and social interactions.

Cancer
PEMF And Cancer
This study examined the effects of whole body magnetic fields (16.5-35 G, 50-165 Hz) on patients suffering from different forms of cancer. Treatment consisted of 15 cycles, each 1-20 minutes in duration, and was coupled with more traditional cancer therapies. Results showed that the magnetotherapy had overall beneficial effects, particularly with respect to improved immune status and postoperative recovery.
V.A. Lubennikov, et al., “First Experience in Using a Whole-Body Magnetic Field Exposure in Treating Cancer Patients,”Vopr Onkol, 41(2), 1995, . 140-141

Diapetic Neuropathy
Neuropathic pain, and specifically peripheral neuropathy, arises from the ectopic firing of unmyelinated C-fibers with an accumulation of sodium and calcium channels. PEMF safely induces low-frequency currents that depolarize, repolarize, and hyperpolarize neurons. Patients had PEMF energy directed into the bottom of the foot. The study found that PEMF therapy significantly reduced pain in 50% of patients.
The QRS device transports the cell waste from the body. Were you aware that the cell waste is sodium and calcium?
Improved
Blood Circulation
A session on the Quantron Resonance System, QRS increases the oxygenation of the cells and tissues, improving mitochondrial function resulting in increased energy.
“Mode of action on the organism by QRS ® on vital blood of a 55-year-old female patient with thyroid carcinoma-clear rouleaux formation (J. Mittelbach, practice for naturopathy, Chemnitz) Picture shows the movement of cells before, during and after treatment.

QRS Therapy…

Ready for Change?
QRS Therapy Improves:
Sleep | Skin Health | Kidney function | Eye Health

Ready for Mental Wellness
QRS Therapy Increases:
Relaxation | Energy and Vitality | Faster Recovery Time From Injuries

Ready to Let Go?
QRS Therapy Reduces
Inflammation | Stress | Migraine Attacks | Chronic Pain